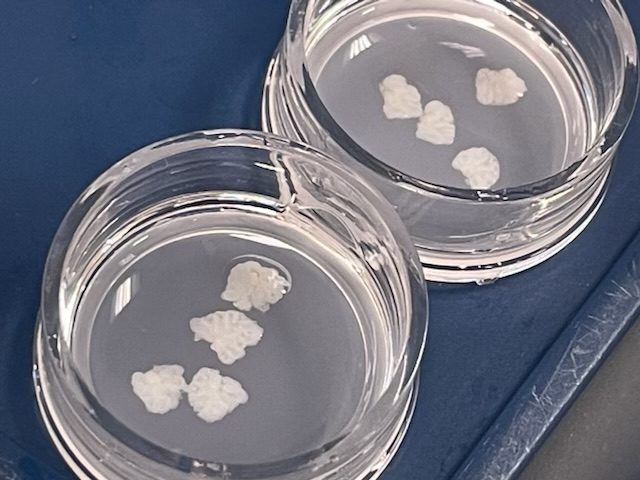

Nos offres
3D-Living Systems
+ Robuste et translatable
+ Physiologique (versus organoïdes,Bioprinting)
+ Personnalisé
+ Alternative aux modèles animaux ou NAM (Novel Alternative Methods)
+ Haut niveau de complexité (= in vivo)
+ Analyses à grande échelle et multiples analyses en parallèle
Suivent la règle des 3R de l'UE :
"Réduire, Remplacer et Raffiner"
Nous RÉDUISONS drastiquement le nombre d'animaux utilisés en recherche.
Microglie présente et fonctionnelle
jusqu'à 4 semaines en culture
et composition en lipides conservée

Valeur ajoutée
Nous modèles précliniques sont des systèmes biologiques physiologiques et intégrés de tissu en 3D, présentant les avantages de l'in vitro (dynamique) et de l'in vivo (physiologique), tout en réduisant le nombre d'animaux utilisés en recherche.
Générés rapidement, il permettent l'accès à tous les types cellulaires, de disséquer les mécanimses à l'echelle moléculaire, cellulaire et tissulaire, ainsi que et le contrôle de l'âge du tissu.
Exemples d'applications

Exemples de modèles 3D personnalisés fournis

Exemples de services fournis

Exemples de projets
Comment se passe concrètement la réalisation d'un projet ?
Exemple 1 : Chercheur de l'industrie pharmaceutique dans le domaine des maladies neurodégénératives
Besoin de :
- cribler des molécules ou de tester la toxicité
- tester un effet neuropotecteur
- de disséquer les mécanismes moléculaires, cellulaires & tissulaires
- de dérisquer avant de passer en in vivo
Exemple 2 : Chercheur dans l'académie en cancérologie (glioblastome)
Besoin de :
- un modèle physiologique pour étudier un mécanisme moléculaire respectant la règle des 3R-5R (alternative aux modèles animaux)
- induire des mécanismes pathologiques (sans recours à des injections stéréotaxiques)
Processus

Pour vous, nous :
- sommes une CRO
- avons l'expertise, les accréditations/autorisations & les accès aux plateformes dédiées
Retours clients
Startup :
« ... après avoir partagé les problématiques que ma société rencontrait, j’ai rapidement perçu ...
passionnée par le vivant ... expertise structurée et qualifiée...
Actuellement en début d’accompagnement avec Research PIECES, nous avons hâte de collaborer pour faire avancer la recherche ensemble »
Laboratoire académique (CNRS) :
« ...les coupes restent en vie pendant 4 semaines, ...on peut suivre les cellules injectées... »
Téléphone: +33 549453725
Courriel: contact@researchpieces.com
Adresse: 1 rue Georges Bonnet, POITIERS, 86000, France
